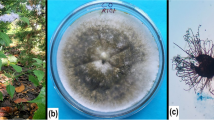

Abstract
1,2-Benzenedicarboxaldehyde-3,4,5-trihydroxy-6-methyl (flavipin) was found to be antagonistic against nematodes and fungi. Here we demonstrated that flavipin is a potent antioxidant in vitro and in vivo, which has great potential in the therapy for free radical-associated diseases. Therefore, flavipin-producing bio-source was screened from 80 endophytes in Ginkgo biloba. Seven endophytic fungi were able to synthesize antioxidant substances and identified by ITS rDNA sequences. Among them, Chaetomium globosum CDW7 was a remarkable producer of flavipin. The fermentation parameters of CDW7 were then optimized for high flavipin production. Cultured under the optimal condition (25 °C, 100/250 mL flask, 12 discs/flask, 150 rpm, pH 6.5) for 14 days, CDW7 was able to synthesize flavipin at a production of 315.5 mg/L. In addition, flavipin output was positively correlated to antioxidant activities of crude extracts with a correlation coefficient of 0.8235, indicating that flavipin was the major antioxidant component of CDW7's metabolites. These data demonstrated that CDW7 was a highly yielded bio-source of antioxidant flavipin.
Similar content being viewed by others
Avoid common mistakes on your manuscript.
Introduction
Increasing evidences demonstrate that reactive oxygen species (ROS) and oxygen-derived free radicals are involved in the degenerative diseases and a variety of pathological effects, such as aging, cancer, atherosclerosis, diabetes, and rheumatoid arthritis (Finkel and Holbrook 2000). Antioxidants treatment is an effective therapeutic approach to prevent or attenuate ROS-associated diseases. Therefore, more attention has been paid to discover potent antioxidants from plants, animals, and microorganisms. Endophytic fungi were recently found to be rich sources for potent natural antioxidants (Huang et al. 2007; Chen et al. 2011; Liu et al. 2010). In our previous fungicidal screening of endophytic fungi from Ginkgo biloba, we found that an endophytic fungus, Chaetomium sp. NJZTP21 (GenBank accession number: JN588553), isolated from the healthy leaf of the plant was able to produce flavipin (Fig. 1), which significantly inhibited the growth of several plant-pathogenic fungi, especially Fusarium graminearum with an IC50 value of 0.73 μg mL−1. Flavipin possesses three phenolic hydroxyl and two aldehyde groups, which are characteristic functional groups with antioxidant activity. However, the antioxidant activity of flavipin has rarely been mentioned (Mapari et al. 2005). In this study, we reported the potent antioxidant activity of flavipin both in vitro and in vivo. In addition, we reported the screening and optimization of endophytic fungi isolated from G. biloba for a highly yielded bio-source of antioxidant flavipin.
Materials and methods
Characterization of flavipin
Flavipin was obtained from endophytic fungi NJZTP21 in our previous study. Its structure was identified by the comprehensive interpretation of its high-resolution ESI-MS (Mariner 8304 high-resolution mass spectrometer), 1H-, and 13C-NMR (Bruker DRX-400 NMR spectrometer) spectra corresponding to that reported by James (2002). The purity of flavipin was confirmed by TLC and HPLC analyses.
Animal use
Kunming mice were purchased from the Comparative Medicine Center of Yangzhou University (Yangzhou, China). All the experiments were performed according to protocols approved by the Animal Use and Care Committee of Nanjing Agricultural University.
Determination of antioxidant capacity for flavipin in vitro
2,2-Diphenyl-1-picrylhydrazyl (DPPH) radical-scavenging capacity assay
The scavenging rate of DPPH radical was carried out by the improved protocol of previous method reported by Skrede et al. (2004). In brief, in 96-well microliter plates, appropriately serial dilution of flavipin (100 μL) was mixed with DPPH reagent (100 μL, 0.2 mmol/L DPPH in ethanol). Ethanol was used as blank while butylated hydroxytoluene (BHT), vitamin C (VC), and 6-hydroxy-2,5,7,8-tetramethylchroman-2-carboxylic acid (trolox) were co-assayed as positive controls. The absorbance of the mixture was read at 515 nm after 0.5 h at 25 °C using microplate reader infinite M200 (Tecan, Switzerland). Antioxidant capacity was evaluated as IC50 (sample concentration that produced 50 % scavenging of the DPPH radical).
Ferric-reducing antioxidant power (FRAP) assay
The FRAP assay was performed according to the previous procedure reported by Benzie and Strain (1996). Specifically, the same dilution described in DPPH assay (20 μL) were mixed with the freshly prepared ferric-tripyridyltriazine (TPTZ) reagent [180 μL, a mixture of 300 mmol/L acetate buffer (pH 3.6), 10 mmol/L 2,4,6-tris(2-pyridyl)-s-triazine in 40 mmol/L HCl, and 20 mmol/L FeCl3 (v/v/v: 10/1/1)]. The absorbance of the reaction mixture was measured at 593 nm after 4 min. The standard curve was established using the ferrous sulfate solutions (range, 0.1–1.0 mmol/L with n = 6 concentrations), and the results were expressed as C0.5FRAP (the concentration of samples with the antioxidant capacity equivalent to that of ferrous sulfate at 0.5 mmol/L).
2,2′-Azinobis(3-ethylbenzothiazoline-6-sulfonic acid) diammonium salt (ABTS) radical-scavenging capacity assay
The ABTS radical-scavenging capacity assay of flavipin was conducted according to the previous method reported by Re et al. (1999). Briefly, K2S2O8 (88 μL, 140 mmol/L) was mixed with ABTS [5 mL, 7 mmol/L in PBS (pH 7.4)]. The mixture was stored in the dark for 12–16 h, and the resulting ABTS radical solution was adjusted to an absorbance of 0.700 ± 0.020 at 734 nm with the addition of PBS. Diluted sample solutions (20 μL) were mixed with ABTS radical solution (180 μL). The mixture was reacted at 37 °C under restricted light for 6 min. The decrease of absorbance at 734 nm was recorded, and the results were evaluated as IC50 (the amount of samples required to decrease the ABTS radical concentration by 50 %).
Fluorescein-oxygen radical absorbance capacity (FL-ORAC) assay
Peroxyl radical absorbance capacity of compounds was tested by using a modified ORAC assay previously described by Dávalos et al. (2004). It was carried out using SpectraMax M5 (Molecular Devices, USA) in a 96-well microplate with fluorescein as a fluorescent probe. All solutions were prepared in phosphate buffer (75 mM, pH 7.4). Briefly, sample solution (20 μL) was mixed with 70 nM disodium fluorescein (120 μL) in a microplate and incubated at 37 °C for 10 min. Afterwards, 2,2′-azobis(2-methylpropionamidine) dihydrochloride (AAPH; 60 μL) preincubated at 37 °C was added to initiate the reaction. Fluorescence was recorded every 2 min thereafter for a duration of 2 h (λ excitation, 485 nm; λ emission, 528 nm). The net area under the curve (AUC) was calculated by subtracting the AUC obtained in presence of an antioxidant from the AUC of the blank. The standard curve of trolox was plotted using a series of concentrations (0.625–10 μmol/L, final concentration). Antioxidant potential of flavipin (2.5 μmol/L, final concentration) was compared with that of trolox. Results were expressed as ORAC units, where 1 ORAC unit equals the net AUC produced by 1 μmol/L of trolox.
Inhibition of microsomal lipid peroxide (LPO)
Mouse liver microsomes used for the LPO studies were prepared adopting the method of Gao and Wang (2012). The adult male mice (8–12 weeks old) were used for the preparation of liver microsomes. The protein content of microsomes was measured using the Bradford method (1976). Microsomes (0.67 mg protein/mL) were incubated at 37 °C for 60 min with test compounds of varying concentrations,10 mM FeSO4 and 0.1 mM ascorbic acid in 1.0 mL potassium phosphate buffer solution (0.2 M, pH 7.4). The reaction was stopped by 20 % (w/v) trichloroacetic acid (1.0 mL) and 0.67 % (w/v) 2-thiobarbituric acid (1.5 mL) in succession, and the solution was then heated to 100 °C for 15 min. After centrifugation of precipitated protein, the color reaction of malondialdehyde (MDA)–TBA complex was detected at 535 nm. Trolox and BHT were the positive control.
In vivo antioxidant activity of flavipin
Aged Kunming mice (10 months old, male, 50–60 g) and young Kunming mice (2 months old, male, 15–20 g) were used in this test. The animals were maintained on a 12-h dark/12-h light cycle at about 22 °C. They had free access to standard laboratory pellet diet and water during the experiments.
After 1 week of acclimatization, the aged mice were randomly divided into two groups (20 mice per group), the aged control group (group I) and flavipin-treatment aged group (group II), while the 20 young mice served as the young control group (group III). Group II mice were administered by oral gavage once a day with a dose of 10 mg/kg flavipin dissolved in physiological saline, and the two control groups were treated with saline solution. Following the 15-day treatment process and 24 h after the last administration, all 60 mice were sacrificed by the humane method of decapitation. Blood were collected and centrifuged at 4 °C (3,500 rpm for 10 min) after 1 h standing at room temperature for the separation of serum. Serum samples were kept at −80 °C until analysis. The liver was surgically excised from the animal, accurately weighed, and then homogenized immediately in ice-cold 0.9 % NaCl solution (0.1 g tissue/mL solution). The suspension was centrifuged at 4,000 rpm at 4 °C for 10 min, and the supernatant was collected for at −80 °C further analysis. The activities of superoxide dismutase (SOD), glutathione peroxidase (GSH-Px), and the level of MDA in the serum and liver were measured using commercially available kits (Nanjing Jiancheng Bioengineering Institute) in accordance with instructions.
Strain resource
Healthy leaves and small branches of G. biloba were collected from healthy plants from April to September 2009 located in Taixing (Jiangsu Province), Nanjing (Jiangsu Province), and Chengdu (Sichuan Province), People's Republic of China. The samples were then stored in valve bags at 4 °C. A total of 80 endophytic fungi were isolated according to the previous method described by Liu et al. (2004).
Identification of the endophytic fungi
Endophytic fungi were identified based on the DNA sequence of ITS1-5.8S-ITS2 (Phongpaichit et al. 2006). DNA was extracted from fungal mycelia grown in PD (potato, 200 g; dextrose, 20 g; H2O, 1,000 mL) medium (25 °C, 150 rpm) for 5 days using Nucleic Acid Purification N1191 (Guangdong Dongsheng Biotech, Guangdong, China). Universal primers of ITS1 (5′-TCCGTAGGTGAACCTGCGG-3′) and ITS4 (5′-TCCTCCGCTTATTGATATGC-3′) were used to amplify the ribosomal internal transcribed region (ITS). The PCR reaction mixture in a total volume of 25 μL containing 1 μL (2.5 U) Taq DNA polymerase, 12.5 μL PCR Kit P2052 (Guangdong Dongsheng Biotech, Guangdong, China), 1 μL (10 μmol/L) of each primer, 8.5 μL H2O, and 1 μL undiluted DNA template was subsequently performed using a DNA Engine Peltier Thermal Cycler (Bio-Rad, USA) with the following cycles: (1) 94 °C for 4 min; (2) 35 cycles of 94 °C for 30 s, 60 °C for 30 s, and 72 °C for 1 min; and (3) 72 °C for 10 min. PCR products were analyzed in 1 % agarose gels by electrophoresis and observed under UV light, after purified with Extract DNA purification kit Cat. DP1501 (Bioteke Corporation, Beijing, China) and then sequenced at Invitrogen Biotechnology Co. Ltd (Shanghai, China). The NCBI BLAST search program was used to search for the closest matched sequences in the GenBank database. The ITS sequences of these active endophytic fungi were submitted to the GenBank (see accession numbers in Table 1).
Preparation of fungal crude extract
Endophytic fungal isolates were grown on a PDA medium (potato, 200 g; dextrose, 20 g; agar, 20 g; H2O, 1,000 mL) at 25 °C for 5 to 10 days. Eight pieces (5 mm diameter) of mycelial agar plugs removed from the edge of young cultures of endophytic fungi were inoculated into each 250-mL Erlenmeyer flasks with 200 mL PD broth medium, followed by shaking (150 rpm) continuously for 12 days at 25 ± 1 °C. The broth culture was filtered to separate the culture broth and mycelia. The culture broth was extracted three times with ethyl acetate (1,000 mL × 3). The ethyl acetate extraction was combined and then dried by using a rotary evaporator. All extracts were kept at 4 °C till analysis.
Screening of flavipin-producing endophytic fungi
Initial screening was based on the antioxidant power of crude extracts from endophytes by the methods of DPPH and FRAP described above. Antioxidant endophytes were further screened with high-pressure liquid chromatography (HPLC). HPLC assays were performed with an Agilent Technologies 1200 Series system consisting of a binary pump with vacuum degasser, a thermostatted column compartment, an autosampler, and a diode-array detector (DAD). Compounds were separated on a Hamilton RPP-1 reversed-phase column (150 × 4.1 mm, 5-μm particle size). The mobile phase consisted of acetonitrile (solvent A) and water with 0.1 % TFA (solvent B). The initial ratio of A to B was 5:95 (v/v), and was changed linearly to 90:10 (v/v) in 10 min, then held constant until 15 min, and finally reset to 5:95 (v/v) where it was held until 17 min when the next sample was injected. The flow rate was 0.5 mL/min. The chromatography was monitored at 265 nm. The retention time of flavipin was 7.97 min (Fig. 1).
Optimization of fermentation conditions
Four different cultures of PD, CD (NaNO3 3 g, K2HPO3 1 g, MgSO4 7H2O 0.5 g, KCl 0.5 g, FeSO4 0.01 g, sucrose 30 g, water 1,000 mL), SD (peptone 10 g, maltose 40 g, water 1,000 mL), and GYT (glucose 5 g, peptone 1 g, yeast extract 0.5 g, beef extract 0.5 g, water 1,000 mL) were chosen to optimize the basic culture medium based on the ethyl acetate crude extracts (EACE) production. One-factor-at-a-time experiment was employed to evaluate the effects of cultural conditions on antioxidant capacity of EACE and flavipin production. Six factors were investigated including temperature (20 °C, 25 °C, 28 °C, and 30 °C), shaking speed (120, 150, 180, and 210 rpm), liquid culture volumes (25, 50, 100, and 150 mL in a 250-mL flask), inoculum size (4, 8, 12, and 16 discs/flask), testing pH (3–10), and fermentation time (8–20 days, every 2 days). Since time was one of the most important factors for the production of metabolites and several factors selected in this study such as culture volumes and inoculum size had interaction with each other, a time tracking method was adopted, that is sampling from the flasks with different factors on the eighth, 12th, and 16th day to optimize the fermentation parameters for the higher flavipin production.
Quantification of flavipin and antioxidant activity of EACE
The EACE of fermentation broth was obtained according to the previously described protocol. The EACE residues ranging from 19.0 to 891.4 mg/L PDB (Table S1 in Supplementary Information) were re-dissolved in acetonitrile (10 mL) for analysis.
Flavipin detection condition was described above. Standard curves were generated using a serial dilution of flavipin (100, 50, 10, 5, and 1 mg/L). There was a linear relationship between the concentration of standard flavipin and area of absorbed peak (r 2 = 0.9991). When spiked with 25.0, 12.5, and 5.0 mg/L flavipin in the fermentation broth with different flavipin production, the recovery rate was between 81.3 % and 92.2 %. Flavipin content analysis was performed according to the formula: M = M 0 × V 1/V 2, where M (milligrams per liter) is flavipin content in fermentation cultures; M 0 (milligrams per liter) is flavipin content in acetonitrile solution (milligrams per liter); V 1 (milliliters) is volume of acetonitrile used in re-dissolving of residues (10 mL); and V 2 (milliliters) is volume of fermentation broths for extraction.
The original solution (EACE redissolved in 10 mL acetonitrile) was diluted with ethanol to make the final concentrations in the test range. Antioxidant capacity was determined using DPPH radical-scavenging capacity assay and evaluated as scavenging rate (percent) of DPPH radical.
Statistical analysis
All the experiments that estimated antioxidant activity were conducted in triplicate, and statistical analysis of the data was performed by analysis of variance (one-way ANOVA), using SPSS 16.0 software. P ≤ 0.05 was considered a statistical significant difference. All data are presented as mean ± standard deviation (SD).
GenBank submission
The partial sequences of ITS1-5.8S-ITS2 region of the strains that displayed antioxidant capacity were submitted to NCBI GenBank and deposited. The accession numbers of each sequence of the endophytes are JN588550-JN588552, JN588554, JN588555, JN793480, and JN793480 (Table 1).
Results
Antioxidant activity of flavipin
The structure of flavipin was identified by comparing its 1H- and 13C-NMR spectra with previously reported data (Sekita et al. 1982; James et al. 2002). The molecular mass weight was determined at m/z 197.0560 [M + H]+ in positive mode ESI-MS (Mariner 8304 high-resolution mass spectrometer). As shown in Table 2, in regard to the ABTS radical-scavenge capacity and peroxyl radical absorbance capacity, flavipin is more potent than BHT, VC, and trolox and comparable to the positive controls with regard to DPPH radicals and ferric-reducing antioxidant ability. Moreover, flavipin exhibited considerable inhibitory activity of the LPO in mice liver microsomes with an IC50 of 1.68 μg/mL compared to that of 83.4 and 58.7 μg/mL of the positive BHT and trolox, respectively. In vivo antioxidant assays (Table 3) showed that flavipin increased the capacities of SOD activity and decrease the content of MDA significantly in serum, and even improve the activities of GSH-Px (797.70 U/mL) in aged mice over the young control group level (694.87 U/mL). Same trends of SOD activity and MDA level in mice liver were observed, while GSH-Px capacity in the liver of the aged flavipin-treatment group was slightly strengthened but with no significant differences to the aged control group. All these results demonstrated that flavipin is a potent antioxidant which has great potential in the therapy for free radical-associated diseases.
Initial screening and identification of antioxidant endophytic fungi
Since flavipin displayed strong activity, it is viable to initially screen antioxidant capacity of crude extracts from endophytic fungi. Among 80 isolates, seven showed antioxidant activities by the screening methods of DPPH radical-scavenging and ferric-reducing antioxidant power, and then were identified as Chaetomium globosum, Schizophyllum commune, Chaetomium sp., Penicillium sp., Phomopsis sp., Colletotrichum gloeosporioides, and Irpex lacteus. As was demonstrated in Table 1, two strains coded CDW7 and NJSP73 revealed better DPPH and ABTS radical-scavenging capacities than BHT, a commercially available potent antioxidant used as the positive reference in this study. Both results of the two methods indicated that the extract from C. globosum CDW7, which had been deposited in China General Microbiological Culture Collection Center (CGMCC) with an accession number 6658, had the strongest antioxidant activity among all the studied endophytic fungi from G. biloba with an IC50 of 6.33 μg/mL in DPPH assay and a C0.5FRAP of 30.78 μg/mL, comparable to those of vitamin C and trolox, the well-known antioxidants co-assayed in this study as the positive control.
Screening of flavipin-producing endophytic fungi
Seven endophytic fungi with antioxidant power described above were further screened for flavipin production according to HPLC detection of their crude extracts. The peak at 7.990 min in HPLC spectrum of crude extracts from strain CDW7 (Fig. 1b) further proved that flavipin (7.973 min, Fig. 1a) was produced. These indicated that C. globosum CDW7 was a remarkable producer of flavipin. 1H-NMR was also employed to screen for the flavipin-producing endophytic fungi, and the results were presented in Supplementary Information (Fig. S1).
Optimization of fermentation conditions
As shown in Fig. 2, PD medium was the best among the four tested media with crude extract production of 357.0 and 568.0 mg/L on the eighth and 12th day, respectively. Figure 3 represented flavipin production under different fermentation conditions using PD medium. The flavipin production under 25 °C on the eighth, 12th, and 16th day were higher than under other temperatures, thus 25 °C was selected as the optimum culture temperature. When the liquid volume was 50 and 100 mL/250-mL flask, the flavipin output were both considerable, and the yield of 50 mL (250.5 mg/L on the 16th day) was slightly better than that of 100 mL (243.4 mg/L on the 16th day). However, the net production of 100 mL was at least twice that of 50 mL, so 100 mL fluid volume was the best fitted. Little differences in flavipin output were found when injected with 8, 12, and 16 discs/flask, but inoculum of 12 discs had a slight advantage and was chosen. The shaking speed of 150 rpm was selected since the strain yielded 300.0 mg/L flavipin on the 12th day, which was completely better than the other speeds. Strain CDW7 was able to grow under pH 3–10 but merely yielded higher flavipin production in pH 6.5, demonstrating that flavipin output was very sensitive to the initial pH and adapted to the slightly acidic environment. After the strain was cultured under the best conditions, flavipin production on the 14th day reached the maximum of 315.5 mg/L with a significant difference compared to the yield at other times; hence, fermentation of 14 days was accounted as the best processing time.
Correlation between flavipin production and antioxidant activity of crude extract
As we can see from Fig. 4, the antioxidant activity of crude extracts was associated with the yield of flavipin with a correlation coefficient of 0.8235, suggesting that flavipin is a very important substance contributing to the antioxidant capacity of the endophytic fungus CDW7.
Discussion
Flavipin was previously reported as a metabolite of Aspergillus flavipes, Aspergillus terreus (Raistrick and Rudman 1956), Epicoccum spp. (Bamford et al. 1961), and C. globosum (James et al. 2002). It was an antagonist against nematodes (James et al. 2002), a potent inhibitor of electron transport and oxidative phosphorylation reactions (White and Elliott 1980), and a potent fungicide against plant pathogenic fungi and bacteria (Madrigal et al. 1991). Flavipin is hypothesized to be a potent antioxidant because it has five antioxidant groups including three phenolic hydroxyl and two aldehyde groups. However, antioxidant capacity of flavipin has rarely been reported. Our findings revealed that the reactivity of flavipin by donating its electrons to the free radicals, its improvement of SOD and GSH-Px activity and decrease of MDA content in the serum and liver of aged mice, and its natural occurrence in the fungus suggested its use as an antioxidant in free radical-meditated physiology and pathology.
Since flavipin displayed strong activity, endophytic fungi from G. biloba were subsequently screened for flavipin-producing endophytes, resulting to that seven exhibited antioxidant activities. These data indicated that the endophytic fungi from G. biloba could be developed as a new reliable source for antioxidant agents. Among the seven endophytes, C. globosum CDW7 was found to be a highly yielded bio-source of natural antioxidant flavipin because it produced 315.5 mg/L broth under the optimal fermentation condition based on HPLC analysis. C. globosum was previously reported as a remarkable producer of bioactive natural products for the fact that it produced globosumones (Bashyal et al. 2005), benzaldehyde derivative Chaetopyranin (Wand et al. 2006), chaetoglobosins (Ding et al. 2006), polyhydroxylated steroids (Qin et al. 2009), etc. In this study, flavipin was proved to be a very important substance contributing to the antioxidant capacity of CDW7 from the correlation between flavipin production and antioxidant activity of crude extract.
References
Benzie IFF, Strain JJ (1996) The ferric reducing ability of plasma (FRAP) as a measure of “antioxidant power” The FRAP assay. Anal Biochem 239:70–76
Bamford PC, Norris GLF, Ward G (1961) Flavipin production by Epicoccum species. Trans Brit Mycol Soc 44:354–356
Bashyal BP, Wijeratne EMK, Faeth SH, Gunatilaka AAL (2005) Globosumones A-C, cytotoxic orsellinic acid esters from the Sonoran desert endophytic fungus Chaetomium globosum. J Nat Prod 68(5):724–728
Bradford MM (1976) A rapid and sensitive method for the quantitation of microgram quantities of protein utilizing the principle of protein-dye binding. Anal Chem 72:248–254
Chen Y, Mao WJ, Tao HW, Zhu WM, Qi XH, Chen YL, Li HY, Zhao CQ, Yang YP, Hou YJ, Wang CY, Li N (2011) Structural characterization and antioxidant properties of an exopolysaccharide produced by the mangrove endophytic fungus Aspergillus sp. Y16. Biores Technol 102:8179–8184
Dávalos C, Gómez-Cordovés C, Bartolomé B (2004) Extending applicability of oxygen radical absorbance capacity (ORAC-fluorescein) assay. J Agr Food Chem 52:48–54
Ding G, Song YC, Chen JR, Xu C, Ge HM, Wang XT, Tan RX (2006) Chaetoglobosin U, a cytochalasan alkaloid from endophyfle Chaetomium globosum IFB-E019. J Nat Prod 69(2):302–304
Finkel T, Holbrook NJ (2000) Oxidants, oxidative stress and the biology of aging. Nature 408:239–247
Gao LW, Wang JW (2012) Antioxidant potential and DNA damage protection activity of aqueous extract from Amillaria mellea. J Food Biochem 36:139–148
Huang WY, Cai YZ, Xing J, Corke H, Sun M (2007) A potential antioxidant resource: endophytic fungi from medicinal plants. Econ Bot 61:14–30
James K, Susan LF, James E, Walter F, David J (2002) Isolation of flavipin, a fungus compound antagonistic to plant-parasitic nematodes. Nematology 4:55–63
Liu J, Luo JG, Ye H (2010) In vitro and in vivo antioxidant activity of exopolysaccharides from endophytic bacterium Paenibacillus polymyxa EJS-3. Carbohyd Polym 82:1278–1283
Liu JY, Song YC, Zhang Z, Wang L, Guo ZJ, Zou WX, Tan RX (2004) Aspergillus fumigatus CY018, an endophytic fungus in Cynodon dactylon as a versatile producer of new and bioactive metabolites. J Biotechnol 114:279–287
Madrigal C, Tadeo JL, Melgarejo P (1991) Relationship between flavipin production by Epicoccum nigrum and antagonism against Monilinia laxa. Mycol Res 95:1375–1381
Mapari SAS, Nielsen KF, Larsen TO, Frisvad JC, Meyer AS, Thrane U (2005) Exploring fungal biodiversity for the production of water-soluble pigments as potential natural food colorants. Curr Opin Biotech 16(2):231–238
Phongpaichit S, Rungjindamai N, Rukachaisirikul V, Sakayaroj J (2006) Antimicrobial activity in cultures of endophytic fungi isolated from Garcinia species. FEMS Immunol Med Microbiol 48:367–372
Qin JC, Zhang YM, Gao JM, Bai MS, Yang SX, Laatsch H, Zhang AL (2009) Bioactive metabolites produced by Chaetomium globosum, an endophytic fungus isolated from Ginkgo biloba. Boorgan Med Chem 19(6):1572–1574
Raistrick H, Rudman P (1956) Studies in the biochemistry of micro-organisms. 97. Flavipin, a crystalline metabolite of Aspergillus flavipes (Bainier and Sartory) Thom and Church and Aspergillus terreus Thom. Biochem J 63:395–406
Re R, Pellegrini N, Proteggente A, Pannala A, Yang M, Rice-Evans C (1999) Antioxidant activity applying an improved ABTS radical cation decolorization assay. Free Radical Bio Med 26:1231–1237
Skrede G, Larsen VB, Aaby K, Jorgensen AS, Birkeland SE (2004) Antioxidative properties of commercial fruit preparations and stability of bilberry and black currant extracts in milk products. J Food Sci 69:351–356
Sekita S, Yoshihira K, Natori S, Udagawa SI, Sakabe F, Kurata H, Umeda M (1982) Chaetoglobosins, cytotoxic 10-(indol-3-yl)-[13]cytochalasans from Chaetomium spp. I. Production, isolation and some cytological effects of chaetoglobosins A-J. Chem Pharm Bull 30:1609–1617
White GA, Elliott WB (1980) Inhibition of electron transport and oxidative phosphorylation in plant mitochondria by gladiolic acid and structurally-related aromatic ortho daildehydes. Can J Biotechnol 58:9–22
Wand S, Li XM, Teuscher F, Li DL, Diesel A, Ebel R, Proksch P, Wang BG (2006) Chaetopyranin, a benzaldehyde derivative, and other related metabolites from Chaetomium globosum, an endophytic fungus derived from the marine red alga Polysiphonia urceolata. J Nat Prod 69(11):1622–1625
Acknowledgments
This work was co-supported by the National Basic Research Program of China (2010CB126104), National Natural Science Foundation of China (30901854), Fundamental Research Funds for the Central Universities (KYZ201107), Special Fund for Agro-scientific Research in the Public Interest (201303023), and Open Research Fund Program of Jiangsu Key Laboratory of Pesticide Science (NYXKT201202).
Author information
Authors and Affiliations
Corresponding authors
Additional information
Yonghao Ye and Yu Xiao contributed equally to this paper.
Electronic supplementary material
Below is the link to the electronic supplementary material.
ESM 1
(PDF 90 kb)
Rights and permissions
About this article
Cite this article
Ye, Y., Xiao, Y., Ma, L. et al. Flavipin in Chaetomium globosum CDW7, an endophytic fungus from Ginkgo biloba, contributes to antioxidant activity. Appl Microbiol Biotechnol 97, 7131–7139 (2013). https://doi.org/10.1007/s00253-013-5013-8
Received:
Revised:
Accepted:
Published:
Issue Date:
DOI: https://doi.org/10.1007/s00253-013-5013-8